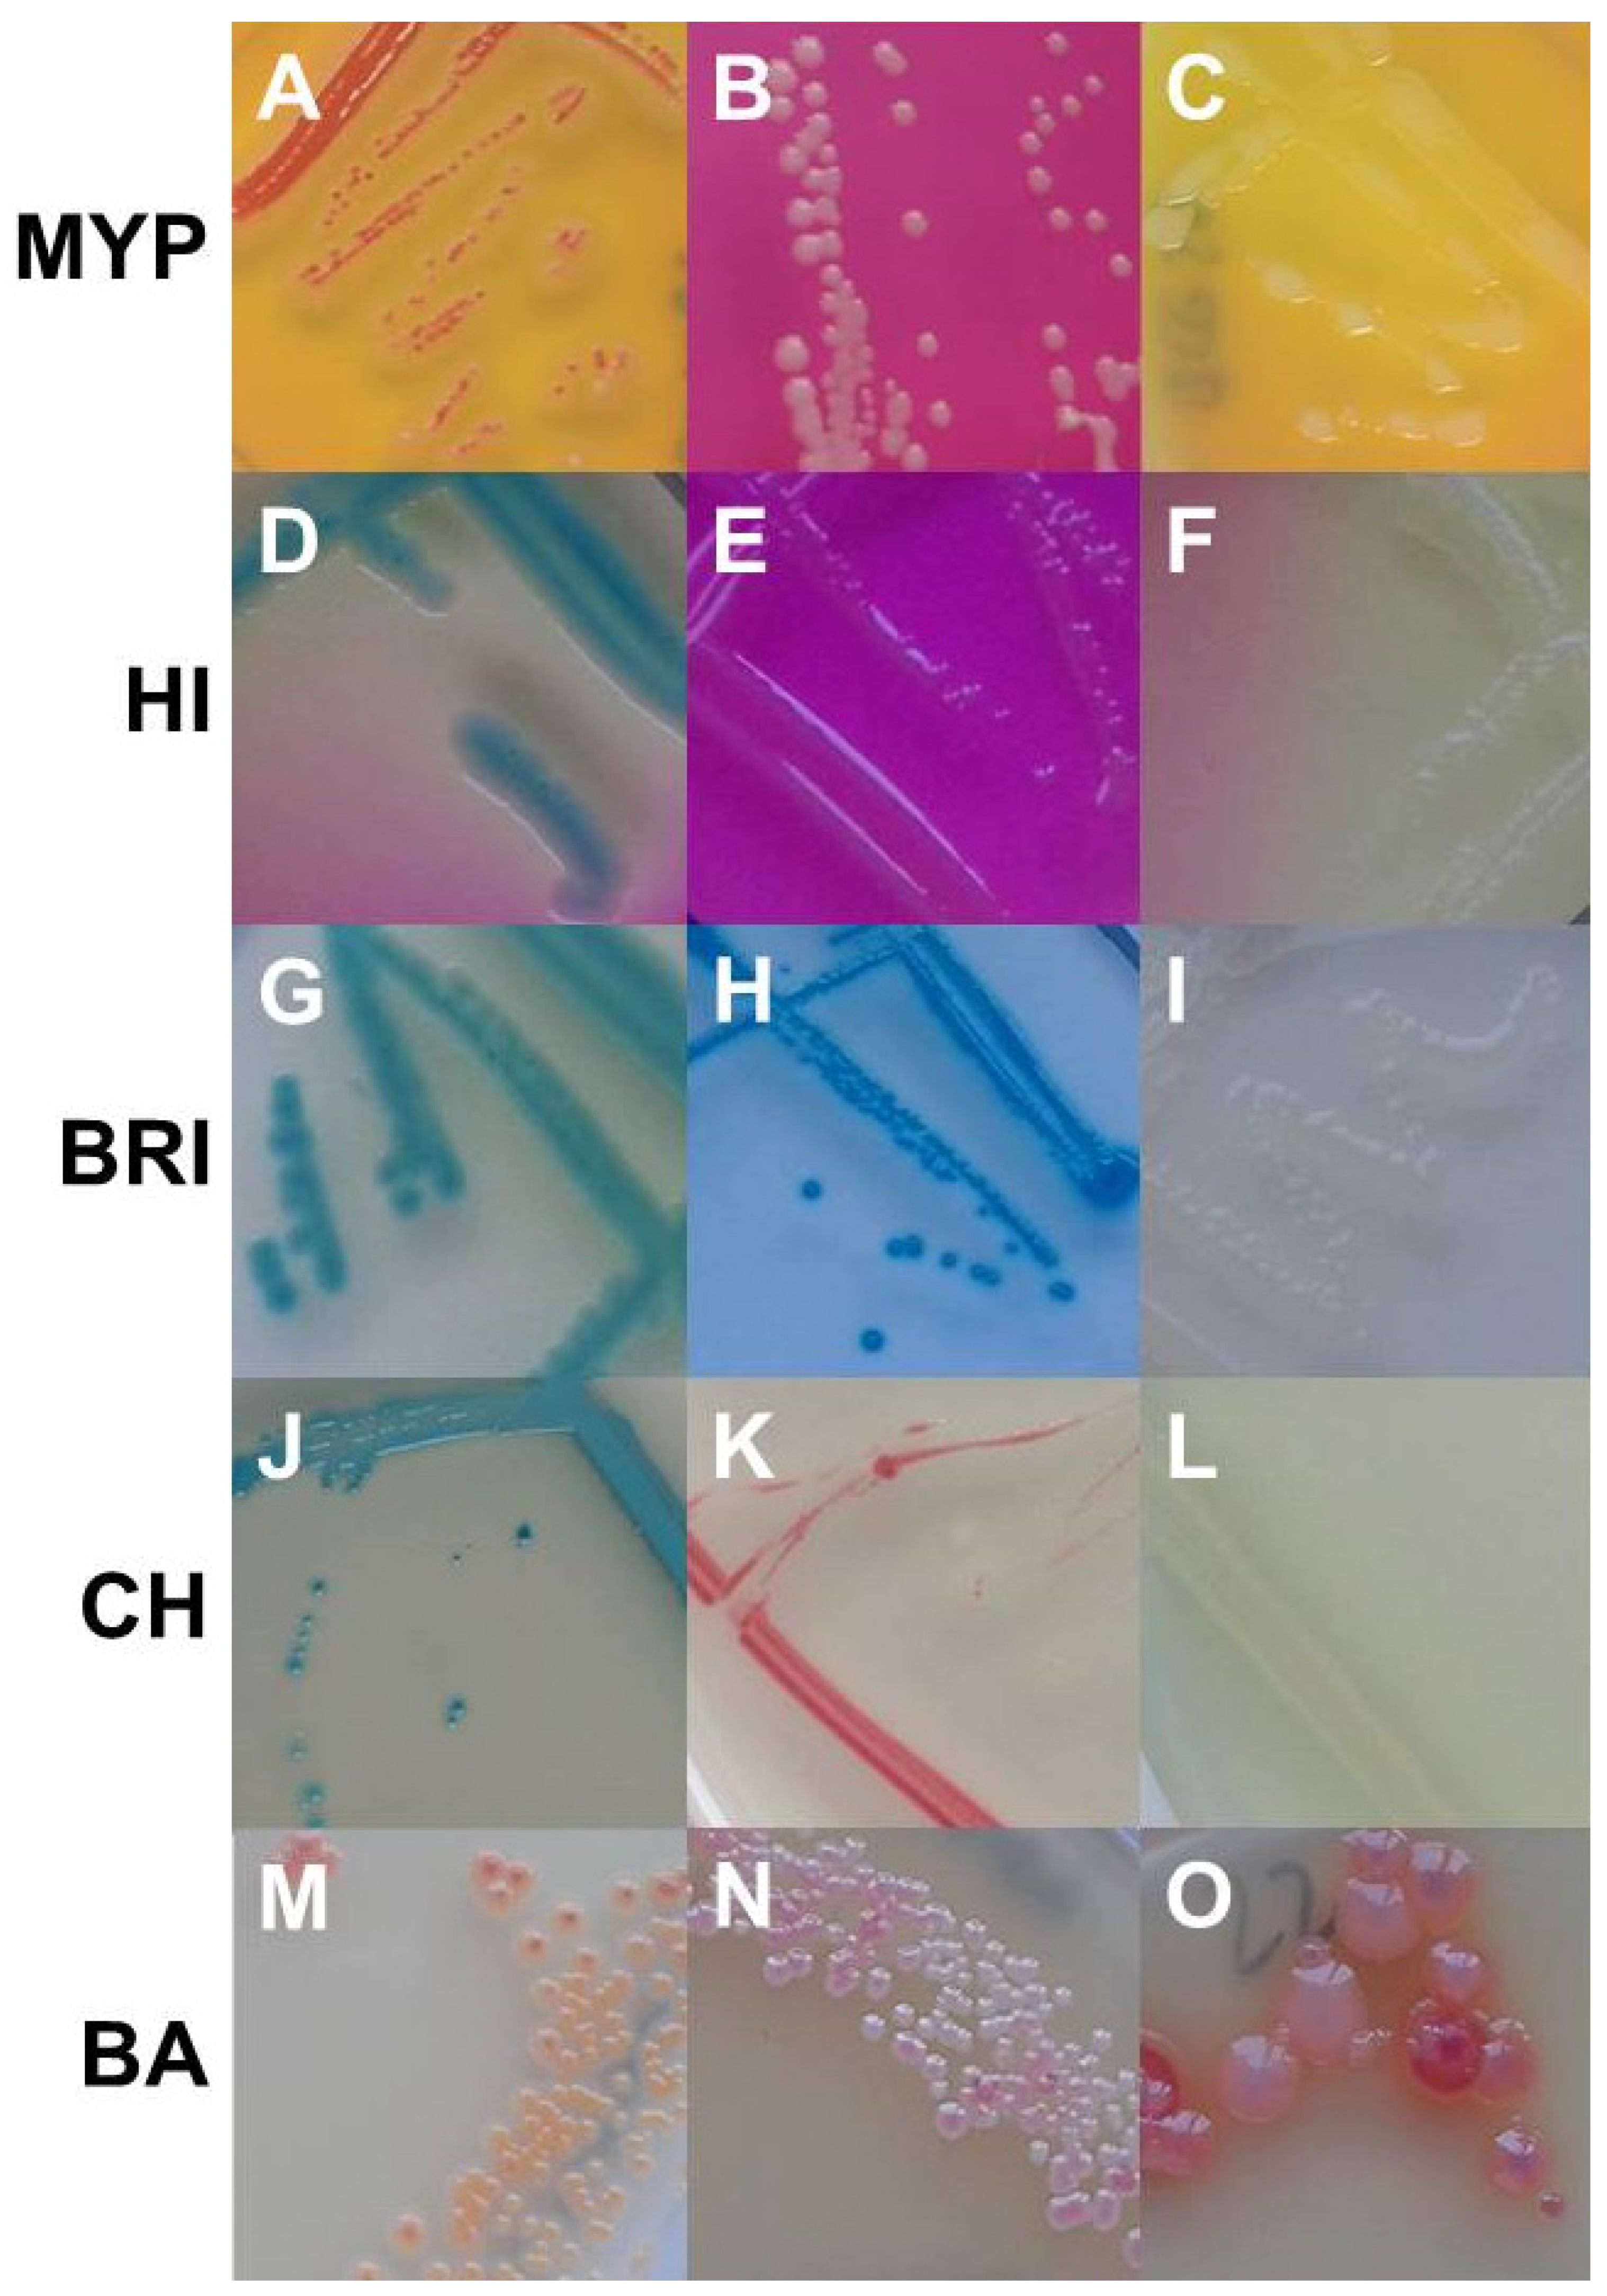
Foods 11 00288 g003
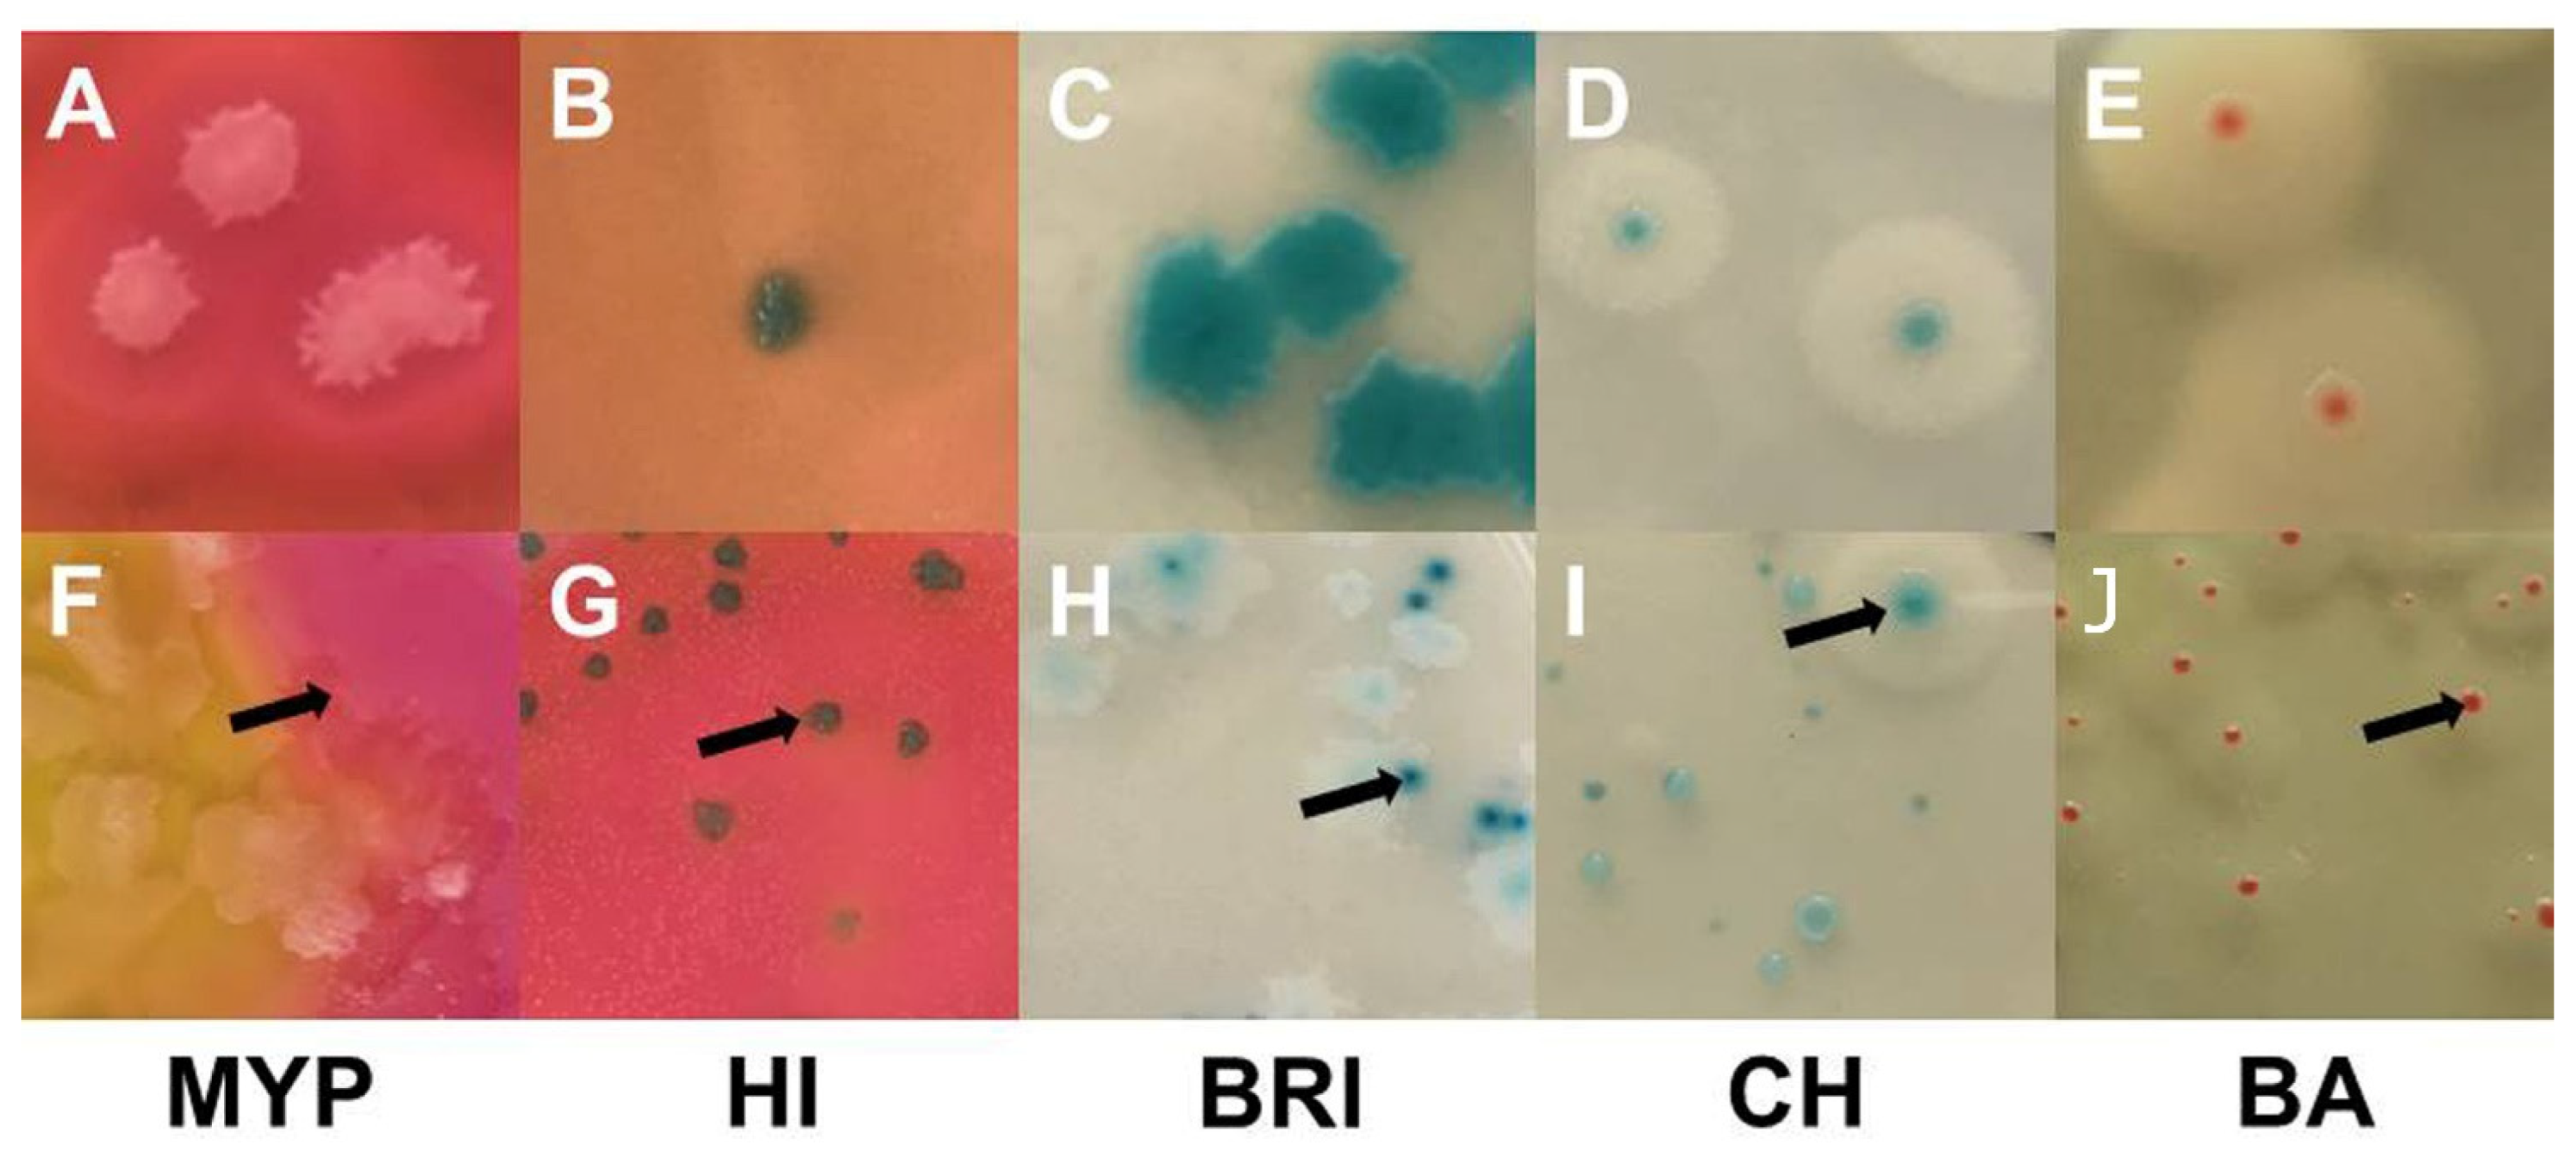
Foods 11 00288 g004

Abstract
In this study, the performance of four alternative selective chromogenic B. cereus agar was compared to the reference mannitol-yolk polymyxin (MYP) agar (ISO 7932) using inclusion and exclusion test strains (n = 110) and by analyzing naturally contaminated milk and other food samples (n = 64). Subsequently, the panC group affiliation and toxin gene profile of Bacillus cereus senso lato (s.l.) isolates were determined. Our results corroborate that the overall best performing media CHROMagar™ B. cereus (93.6% inclusivity; 82.7% exclusivity) and BACARA® (98.2% inclusivity, 62.7% exclusivity) are more sensitive and specific compared to Brilliance™ B. cereus, MYP and ChromoSelect Bacillus Agar. Both media allow unequivocal detection of B. cereus with low risks of misidentification. Media containing ß-D-glucosidase for the detection of presumptive B. cereus may form atypical colony morphologies resulting in a false negative evaluation of the sample. Naturally contaminated samples presented high numbers of background flora, while numbers of presumptive B. cereus were below the detection limit (<10 CFU g−1 or mL−1). Recovery after freezing resulted in the highest detection of B. cereus s.l. on BACARA® (57.8%), CHROMagar™ B. cereus (56.3%) and MYP agar (54.7%). The panC/toxin profile combination IV/A was the most abundant (33.0%), followed by III/F (21.7%) and VI/C (10.4%). More panC and toxin combinations were present in 15.6% of samples when reanalyzed after freezing. In order to improve detection and confirmation of B. cereus s.l. in food samples, we recommend the parallel use of two complementary selective media followed by molecular characterization (e.g., panC typing combined with toxin gene profiling). When determining psychrotolerant or thermophilic members of the B. cereus group, the selective agar media should additionally be incubated at appropriate temperatures (5 °C, ≥45 °C). If high-risk toxin genes (e.g., ces or cytK-1) are detected, the strain-specific ability to produce toxin should be examined to decisively assess risk.
1. Introduction
Bacillus senso latu (s.l.) consists of Gram-positive, rod-shaped, aerobic or facultative anaerobic spore-forming bacteria that are widespread in the environment and commonly found in soil, plant material and in the gut of insects [1,2,3]. As toxin producers and food spoiling bacteria, they pose a health risk and cause economic damage when entering and persisting in the food chain [4,5,6].
The B. cereus s.l. group is represented by B. cereus s.s., B. anthracis, B. cytotoxicus, B. mycoides, B. pseudomycoides, B. thuringiensis, B. toyonensis and B. weihenstephanensis [2,7,8,9,10].
In order to protect consumer health, a process criterion for presumptive B. cereus in infant formulas (≤500 colony forming units [CFU] g−1) was set within the Commission Regulation (EC) No 1441/2007 (EC, 2007; https://eur-lex.europa.eu/legal-content/EN/TXT/HTML/?uri=CELEX:32007R1441&from=EN; accessed on 17 December 2021). In addition, warning values are available, for example, for dried herbs and spices; tofu and bakery products (4 log CFU g−1); or fruits and vegetables, cereals, pasta, mayonnaises, dressings, soups and ready-to-eat instant products (3 log CFU g−1) (https://www.dghm-richt-warnwerte.de/de/dokumente; accessed on 17 December 2021).
In current practice, presumptive B. cereus s.l. is detected and enumerated on classical culture media as for example mannitol egg yolk polymyxin (MYP) agar. Chromogenic reactions rely on enzymatic cleavage (e.g., by β-D-glucosidase) of a particular substrate and the release of a chromogen, which is more specific than conventional microbiological growth media. Some chromogenic media additionally detect PLC activity in order to facilitate unambiguous identification. Selectivity is achieved in both media types by the addition of antibiotic substances (e.g., polymyxin B or trimethoprim), which inhibit the growth of undesirable Gram-positive and Gram-negative bacteria [11,12].
Apart from B. cereus s.l. counts, strain-specific properties such as toxin gene profiles or other virulence factors need to be investigated for risk characterization efforts. A broad range of phenotypical (e.g., biochemical profile, growth behavior and σ-endotoxin crystal staining) and genotypical methods (e.g., Multilocus Sequence Typing (MLST) and panC-typing) are required to accurately identify and group B. cereus s.l. on the species level [13,14,15], rendering species differentiation difficult under routine laboratory conditions.
Fourier transform infrared (FTIR) spectroscopy and Matrix-Assisted Laser Desorption/Ionization Time of Flight (MALDI-TOF) Mass Spectrometry have been developed to speed up the identification and characterization of B. cereus s.l. and cereulide. However, database richness is decisive for accurate species identification, and an enhanced cloud-based exchange of spectral data would be necessary for propagation [16,17,18,19,20].
As many innovative methods are established exclusively in expert’s laboratories, there is still the need for rapid and unambiguous isolation and differentiation methods applicable in food and dairy plant laboratories. Contemporary chromogenic media may represent a useful tool to facilitate identification of B. cereus s.l. and accelerate the time to result by easier visual evaluation of morphology and color changes of media.
This study was initiated to assess and compare the performance of the ISO standard medium MYP agar with four alternative chromogenic selective plating media for detection and enumeration of food-intoxication and spoilage-associated B. cereus group members by using a bacterial test strain panel and analyzing naturally contaminated samples under everyday conditions. Furthermore, an in-depth molecular-biological characterization of inclusivity test strains and sample isolates was performed to explore strain-specific features.
2. Materials and Methods
2.1. Performance Testing of Selective Media
2.1.1. Test Media
Within the scope of this study, the performance of commercially available chromogenic selective media ChromoSelect Bacillus (HI; Merck KgaA, Darmstadt, Germany; formerly branded HiCrome™ Bacillus), CHROMagar™ B. cereus (CH; CHROMagar, Paris, France), Brilliance™ B. cereus (BRI; Thermo Fisher Scientific Inc., Oxoid, Waltham, MA, USA) and BACARA® agar (BA; B. cereus Rapid Agar; bioMérieux, Marcy l’Etoile, France) was evaluated in comparison to the ISO recommended standard medium MYP [21] (Thermo Fisher Scientific Inc., Oxoid, Waltham, MA, USA). Information on media composition—as indicated in the media manufacturer’s specifications—is listed in Supplementary Table S1.
2.1.2. Inclusivity and Exclusivity Test Strains
In order to evaluate the performance of B. cereus selective media, a bacterial test strain panel (n = 220) consisting of B. cereus target organisms (for inclusivity testing, n = 110) and non-target Bacillus spp. (for exclusivity testing, panel included spoilage-associated microbes and Gram–positive and Gram–negative competitors; n = 110) was compiled. B. cereus s.l. strains originated from emetic and diarrheal outbreaks (Institute for Microbiology strain collection, University of Veterinary Medicine Vienna), environmental samples, fruits and vegetables, cereals, fish, tea, herbs, spices, milk and dairy products (isolate collection Unit of Food Microbiology, University of Veterinary Medicine Vienna; Supplementary Table S2). Exclusivity strains were selected according to their relevance and frequency as food contaminants and covered, among others, isolates deriving from fruits and vegetables, meat and meat products, dried spices and seeds, milk products and dairy processing environments (Supplementary Table S3). All strains are preserved as cryogenic cultures (Corning, VWR, Vienna, Austria) in a volume of 1.5 mL brain heart infusion broth (BHI; Merck KGaA, Darmstadt, Germany) with 15% glycerol (Merck KGaA) at −80 °C (GFL Gesellschaft für Labortechnik GmbH, Großwedel, Germany) in the strain collection of the Unit of Food Microbiology.
After activation of test strains from glycerol stocks and subculturing on trypto-casein-soy agar plus 0.6% yeast (TSA-Y; Biokar Diagnostics, Beauvais, France), selective media were inoculated. In order to obtain a few well-defined bacterial colonies, an isolated single colony from the working culture was transferred onto selective B. cereus media by fractioned three loop inoculation. After incubation (Ehret GmbH & Co. KG, Emmendingen, Germany) at the specified conditions (Supplementary Table S1), the presences of bacterial growth and colony morphology were recorded for all media. By qualitative classification into “typically growing,” “atypically growing”, or “non-growing” strains, media benefits and limitations were determined.
2.1.3. Naturally Contaminated Food Samples
In order to evaluate media reliability under routine laboratory conditions, food samples (n = 64) from 18 producers were collected from the production chain and retail level. Food samples (20.3%, n = 13/64; producer A–F) belonged to the source categories “fruits and vegetables”, “nuts, nut products and seeds”, “fish and fishery products”, “herbs” and “cocoa and cocoa preparations, coffee, and tea” (Supplementary Table S4A). Milk samples (79.7%, n = 51/64; producer G-R) were heat treated, except for one raw milk sample (bactofugation) provided by a local dairy (Supplementary Table S4B).
Important information regarding processing was gathered, including the type of milk with reference to animal species (cow or small ruminant), agricultural system (organic or conventional farming), processing and predicted shelf-life (homogenized, pasteurized or high pasteurized) (Supplementary Table S4B). The majority of milk samples (80.4%, n = 41/51) were produced organically. Milk samples were examined after 24 h provocation at 30 °C for enrichment to ensure detection of B. cereus s.l. All food samples were analyzed before and after freezing at −20 °C to trigger outgrowth of spores.
In order to prepare sample homogenates, 25 mL or 25 g of food product was diluted 1:10 in sterile buffered peptone water (BPW; Fisher Scientific Inc., Oxoid); food samples were additionally mixed for 180 s in a paddle blender (Stomacher®; Seward Ltd., West Sussex, UK). Ten-fold serial dilutions in sterile Ringer’s solution (B. Braun Melsungen AG, Melsungen, Germany) were plated in duplicate up to 10−5 on selective agar media by using the spatula method. Following incubation, growth was assessed, and colonies displaying characteristic morphology were enumerated to determine the extent of B. cereus s.l. contamination. Randomly picked colonies with typical and atypical morphology were isolated, subjected to confirmation and characterized with regard to panC group affiliation and toxin gene profile.
2.2. Molecular and Phenotypical Characterization
2.2.1. DNA-Extraction
Bacterial DNA was extracted from B. cereus s.l. cultures grown overnight on TSA-Y at 30 °C (Biokar Diagnostics and Merck KGaA) using the Chelex® 100 resin (Bio-Rad Laboratories, Inc., Hercules, CA, USA) method as described by Walsh et al. [22]. After extraction, 100 µL DNA of each isolate was kept at −20 °C until use in characterization experiments.
2.2.2. Confirmation of Group Affiliation
Bacillus cereus s.l. strains from culture collections and presumptive isolates from naturally contaminated food products and milk were confirmed as group members by PCR method targeting the gyrase B gene (gyrB) as described by Dzieciol et al. [23].
2.2.3. Toxin Gene Screening and Profiling
Confirmed B. cereus s.l. strains were screened for their toxin gene content by conventional PCR assays. Amplification was performed according to Ehling-Schulz et al. [24] with minor modifications, addressing the most widespread toxin genes. Two genes of the NHE-complex and two genes of the HBL-complex were taken into consideration: the enterotoxin genes nheA, nheB, hblA and hblD. Furthermore, PCR pre-screening assay were applied for cytK-1/cytK-2. Detection of the emetic toxin cereulide gene ces was performed after Dzieciol et al. [23] with slight adjustments. Strain-specific toxin gene profiles were assigned based on prevailing toxin gene combinations as in Ehling-Schulz et al. [24] (Figure 5, Supplementary Tables S2 and S6).
2.2.4. Partial panC Sequencing
Amplification, purification and sequencing (LGC, Berlin) of a fragment of the pantothenate synthetase (panC) gene were conducted as previously reported [13]. In order to assign B. cereus s.l. strains to one of the seven major phylogenetic groups (i.e., I-VII) defined by Guinebretière et al. [13,25], sequences were matched with deposited sequences in a web-based database (https://www.tools.symprevius.org/Bcereus/english.php, accessed on 17 December 2021) (Figure 5, Supplementary Tables S2 and S6).
2.2.5. Assessment of Hemolytic Activity
β-hemolytic activity of inclusivity test strains was determined on Columbia agar plates containing 5% sheep blood (COS; bioMérieux) after overnight incubation at 30 °C [21] (Supplementary Table S2).
2.3. Evaluation Criteria and Statistics
In order to differentiate the phenotypic appearance of test strains and evaluate their potential for misidentification, the growth of inclusivity and exclusivity strains was classified in typical and atypical according to their reaction(s) and colony morphology on selective media (Figure 1).
A mosaic plot was used for visualizing the results of growth and phospholipase C reactions of inclusivity and exclusivity test strains for each of the tested media MYP, HI, BRI, CH and BA (Figure 1). Detectability of B. cereus s.l. in naturally contaminated samples was illustrated in a bar plot (Figure 5). The relative frequency of panC group (II–VI) and toxin gene profile (A–F) combinations among B. cereus s.l. isolates (n = 106) associated with naturally contaminated samples was depicted as pie chart (Figure 6). Graphics were created with open-source statistical computer environment R version 4.1.0 [26].
3. Results
3.1. Inclusivity and Exclusivity Testing
The detailed strain properties of the inclusivity test strains are presented in Supplementary Table S2. The majority of inclusivity test strains (n = 110) were assigned to toxin profile C (nhe+/hbl+; 33.6%, n = 37) and A (nhe+/hbl+/cytK+; 27.3%, n = 30). The ces gene was present in six (5.5%) test strains derived from foodborne outbreaks. Among the target test strains, panC group III (30.9%, n = 34), IV (30.0%, n = 33) and VI (20.0%, n = 22) were the most abundant. The most frequent combination of panC group and toxigenic profile in the entire panel of inclusivity test strains was IV/A (21.8%, n = 24), obtained from milk and dried products (such as tea, spices and mushrooms). Other common combinations were VI/C (17.3%, n = 19) isolated from milk, soil and salad, as well as III/D (10.9%, n = 12) mainly detectable in strains isolated from protein-rich food (e.g., feta, dried fish and mushrooms).
Examination of target strains showed >99% inclusivity on all media (n = 109–110/110); one B. pseudomycoides strain did not grow on three selective media (Figure 1). The highest rates of atypical β-D-glucosidase negative colonies were observed on BRI (12.7%, n = 14), HI (6.4%, n = 7) and CH (5.5%, n = 6), resulting in an atypical white phenotype (Figure 2 and Supplementary Table S2). Such colony morphologies were largely related to the milk- or soil-derived panC-type/toxin profile VI/C. On chromogenic media (CH and BA), the PLC reaction was more distinct in comparison to MYP agar (Figure 2).
Figure 1.
Growth (a,c) and phospholipase C reaction (b,d) of inclusivity (n = 110) and exclusivity (n = 110) test strains. Negative is no-growth, positive is typical growth and atypical is not presumptive Bacillus cereus sensu lato morphology on selective agar media. Abbreviations: PLC—phospholipase C; MYP—mannitol egg yolk polymyxin agar; CH—CHROMagar™ B. cereus; BA—BACARA® agar; HI—ChromoSelect Bacillus agar; BRI—Brilliance™ B. cereus agar.
Figure 2.
Typical (A–E) and atypical colonies (F–J) of Bacillus cereus sensu lato on MYP agar (A (BCG 6), F (BC 66)), ChromoSelect Bacillus agar (B (BC 30), G (BC 20)), Brilliance™ B. cereus agar (C (BC 2), H (BC 19)), CHROMagar™ B. cereus (D (BC 63), I (BC 2)) and BACARA® agar (E (BC 50), J (BC 34)). Bluish-green colonies are the result of β-D-glucosidase reaction. Precipitation zones surrounding typical colonies are caused by phospholipase C reaction, while lack of mannitol fermentation results in pink background. Abbreviations: MYP—mannitol egg yolk polymyxin agar; HI—ChromoSelect Bacillus agar; BRI—Brilliance™ B. cereus agar; CH—CHROMagar™ Bacillus cereus; BA—BACARA® agar.
Best performing media in terms of exclusivity (Supplementary Table S3) were CH (82.7%, n = 91/110) and BA (62.7%, n = 69/110). Several non-target organisms were not effectively suppressed by polymyxin B in MYP and (82.7%, n = 91/110) and HI (88.2%, n = 97/110) (Figure 3 and Supplementary Table S3). Comparatively low inhibition of exclusivity strains (n = 110) was also observed on BRI (60.9%, n = 67), although we only observed colony morphologies that could not be misidentified as presumptive B. cereus due to their atypical pin-point growth (Figure 3).
Figure 3.
Growth of non-target organisms on Bacillus cereus selective media (from upper left to lower right). MYP agar: (A)—Serratia marcescens (EGN 54); (B)—Brochothrix thermospacta (EGP 2); (C)—Bacillus stratosphericus (BG 28). ChromoSelect Bacillus agar: (D)—Aeromonas hydrophila (EGN 5); (E)—Acinetobacter baumannii (EGN 2); (F)—Citrobacter freundii (EGN 9). Brilliance™ B. cereus agar: (G)—Staphylococcus sciuri (EGP 13); (H)—Serratia marcescens (EGN 54); (I)—Pseudomonas fluorescens (EGN 45). CHROMagar™ B. cereus: (J)—Morganella morganii (EGN 39); (K)—Enterococcus faecalis (EGP 5); (L)—Providencia rettgeri (EGN 42). BACARA® agar: (M)—Staphylococcus haemolyticus (EGP 11); (N)—Staphylococcus chromogenes (EGP 9); (O)–Listeria monocytogenes (EGP 22). Abbreviations: MYP—mannitol egg yolk polymyxin agar; HI—ChromoSelect Bacillus agar; BRI—Brilliance™ B. cereus agar; CH—CHROMagar™ Bacillus cereus; BA—BACARA® agar.
PLC reaction typical for the target organisms was observed in three and two exclusivity tests strains on MYP and BA, respectively (Listeria monocytogenes, Paenibacillus polymyxa and Serratia marcescens).
3.2. Naturally Contaminated Samples
Milk (n = 51) and food (n = 13) samples analyzed were contaminated with presumptive B. cereus at the limit of detection, resulting in quantitative data below 10 and 100 CFU g−1, respectively. Further details on sample characteristics can be found in Supplementary Table S4A,B. Typical and atypical B. cereus s.l. colonies grown on selective media test panel are shown in Figure 4.
Figure 4.
Examples of typical Bacillus cereus sensu lato colonies obtained by sampling of naturally contaminated food ans milk samples. Demarcated colonies with typical morphology (top row): (A)—MYP agar (ESL-milk); (B)—HI, ChromoSelect Bacillus agar (ESL-goat milk); (C)—Brilliance™ B. cereus agar (ESL-milk); (D)—CHROMagar™ B. cereus (ESL-milk); (E)—BACARA® agar (ESL-milk). Colonies masked by high growth of background flora and atypical morphologies (bottom row; arrows point on typical B. cereus colonies): (F)—coalescing B. cereus colonies surrounded by mannitol-positive background-flora (B. licheniformis) on MYP agar (dried fish snack); (G)—mixed culture on ChromoSelect Bacillus agar, growth of mannitol-positive background-flora (Staphylococcus spp.) intersparsed with typical colonies (raw milk); (H)—atypical light colonies with weak β-D-glucosidase activity and typical colonies on Brilliance™ B. cereus agar (ESL-milk); (I)—atypical PLC-negative and weakly β-D-glucosidase positive colonies lacking the distinctive halo together with typical colony on CHROMagar™ B. cereus (Chinese water spinach); (J)—atypical small colonies with weak PLC acitivity on BACARA® agar (dried fish snack). Abbreviations: MYP—mannitol egg yolk polymyxin agar; HI—ChromoSelect Bacillus agar; BRI—Brilliance™ B. cereus agar; CH—CHROMagar™ B. cereus; BA—BACARA® agar.
Figure 5 shows the B. cereus group containing samples with respect to the distribution of the panC group in combination with toxin profiles. The samples were negative in PCR confirmation of the emetic toxin gene (ces); in consequence, the toxin profiles B (nhe, hbl, ces gene combination positive) and E (nhe and ces gene combination positive) were not detected. The panC/toxin profile combination IV/A was the most abundant in the sample set (33.0%), followed by III/F (21.7%) and VI/C (10.4%). Representatives of panC group IV are described as highly cytotoxic and do generally grow at temperatures ≥10 °C. Toxin profile A represents nhe, hbl and cytK gene (cytK-2) positive isolates. The enterotoxin genes nhe, hbl and cytK-2 are located in the chromosome of different species of the B. cereus group, whereas the cytK-1 gene is harbored exclusively by thermophilic species B. cytotoxicus (panC group VII). Representatives of panC group VII were not detected in any sample. panC group III is considered highly cytotoxic and is representative of B. cereus group grown at temperatures of ≥15 °C. The carriage of nhe gene (non-hemolytic enterotoxin) characterizes toxin profile F. Strains affiliated to panC group VI, which low cytotoxic and grown at ≥5 °C. Toxin profile C is characterized by the presence of nhe and hbl genes [24] (https://www.tools.symprevius.org/bcereus/english.php; accessed on 17 December 2021).
Figure 5.
Combinations of panC groups (II–VI) and toxin gene profiles (A–F) of Bacillus cereus sensu lato isolates obtained from 64 naturally contaminated samples. Abbreviations: A—toxin profile A (nhe+, hbl+ and cytK+); C—toxin profile C (nhe+ and hbl+), D—toxin profile D (nhe+ and cytK+); F—toxin profile F (nhe+); II—panC group II (cytotoxic, growth ≥7 °C); III—panC group III (cytotoxic-highly cytotoxic, growth ≥15 °C); IV—panC group IV (highly cytotoxic, growth ≥10 °C); V—panC group V (low cytotoxic, growth ≥8 °C); VI—panC group VI (non or low cytotoxic; growth ≥5 °C).
Naturally contaminated samples were initially pre-screened for the presence of presumptive B. cereus s.l. on MYP agar prior to freezing (67.2%, n = 43 positive). Recovery after freezing was tested using the selective media test panel, and it resulted in the highest recovery on BA (57.8%, n = 37), CH (56.3%, n = 36) and MYP (54.7%, n = 35) (Figure 6). Supplementary Table S5 indicates that samples tested negative on MYP before freezing were positive for some of the selective media after freezing. The highest accordance (n = 6) for presumptive B. cereus s.l. recovery before and after freezing was observed for milk samples of different origin. panC group and toxin gene profile combinations of B. cereus s.l. detected before and after freezing are provided in Supplementary Table S6. In 13 of 64 samples (20.3%), panC group and toxin profile combinations were identical before and after freezing. In 12 (18.8%) and 16 samples (25.0%), respectively, B. cereus s.l. was detectable either only before or after freezing. In 13 samples (20.3%), different panC and toxin combinations were detectable after freezing in comparison to analysis before freezing.
Figure 6.
Detectability of Bacillus cereus sensu lato in 64 naturally contaminated food samples before freezing on MYP agar and after freezing on MYP agar and chromogenic media. Abbreviations: MYP—mannitol egg yolk polymyxin agar; BA—BACARA® agar; CH—CHROMagar™ Bacillus cereus; BRI—Brilliance™ B. cereus agar; HI—ChromoSelect Bacillus agar.
4. Discussion
B. cereus s.l. is documented among the most prevalent foodborne pathogens, causing one third of food poisoning events in Europe [27].
The presence of B. cereus s.l. in food depends mainly on the contamination of the raw material, as well as on recontamination during processing and extrinsic and intrinsic growth conditions during storage. This results in an increased likelihood of disease-relevant concentrations in minimally processed foods consumed either raw or unheated or in inadequately stored extended shelf-life (ESL) products (e.g., in case of cold storage interruption or accidental household refrigerator temperature abuse) [28,29,30,31]. In addition, the availability of nutrients and other extrinsic factors can influence toxin levels formed in the food matrix. In particular, high starch, carbohydrate, vitamin, trace element content, neutral pH and moderate to high water activity have been shown to be associated with increased risk of cereulide formation [32].
The detection of presumptive B. cereus requires microbiology-trained personnel and is labor-intensive if samples are comprehensively assessed. Most commonly, detection and confirmation are performed using selective culture media such as MYP agar according to ISO 7932 [21]. In industry, samples are often plated on MYP or PEMBA agar and a further discrimination is pursued. Sample analysis is challenged if a high level of accompanying flora jeopardizes outreads since other microbes will stain the agar yellow due to mannitol consumption. As a result, individual colonies of presumptive B. cereus s.l. are missed in the yellow-stained agar, and the sample is often considered false negative by the investigator.
This study focused on the comparison of alternative chromogenic selective nutrient media to identify the best performer for B. cereus s.l. detection and enumeration. For this purpose, inclusivity and exclusivity were elicited, and group diversity was determined by using naturally contaminated samples before and after freezing.
The study of B. cereus s.l. strains showed an inclusivity of >99% for all media, which is in general very promising. Nevertheless, atypical colony morphologies may occur. The highest rates of atypical β-D-glucosidase negative colonies were observed on BRI (12.7%, n = 14), HI (6.4%, n = 7) and CH (5.5%, n = 6) agar, resulting in a white phenotype. Atypical morphologies were largely related to the milk-derived or soil-derived panC-type/toxin profile combination VI/C. These atypical B. cereus s.l. phenotypes appear to be niche-specific and may possibly be associated with specific panC types with variable exploitability of starch and various carbohydrates in the genetic clade. For instance, panC group IV comprises strains isolated from vegetables indicated limited substrate utilization pathways. Furthermore, a sub-branch within panC group III showed the least carbohydrate fermentation capacity due to a lack of aryl-6-phospho-β-glucosidase-encoding genes in the genome [33].
Previous studies focusing on agar evaluations also reported ß-D-glucosidase-negative B. cereus s.l. colonies on chromogenic B. cereus media manufactured by Oxoid or BMC-Biosynth, which is a concern for a proper evaluation [11,12,34]. In contrast, Chon et al. [35] showed increased specificity and selectivity of BRI agar in foods with high background microbial load and particularly recommended this agar for quantitative analysis. In a comparative analysis of BA and BRI agar, these two culture media were clearly superior to conventional culture media, with BRI agar being more efficient and selective for B. cereus s.l. isolation in this setting [36]. In a more recent comparison of the standard media MYP, PEMBA, BRI and a novel—yet not commercially listed—chromogenic agar medium (BCCA), atypical colony morphologies were also described on BRI agar (dark blue color) [37]. BCCA was based again on the detection of ß-D-glucosidase comparable to the BRILLIANCE agar and was fortified by polymyxin B (100,000 IU), trimethoprim (10 mg), ceftazidime (16 mg) and egg yolk emulsion (50 mL). This alternative medium seemed to be more selective in comparison to MYP and PEMBA and circumvented the false negative diagnosis of atypically grown presumptive B. cereus colonies by additional lecithinase reaction. All this research shows that B. cereus s.l. analysis is demanding and that current media are not sufficiently selective to analyze the diversity of the group.
According to literature, the presence of PC-specific or PI-specific PLC is widespread among B. cereus s.l. Almost all group isolates were PLC-positive in the literature: 96% [38] and 93% [39] or 100% PLC and 83% PI-PLC positive isolates [40]. The best performer in the detection of PLC reaction mediated by phosphatidyl-inositol (PI) or phosphatidyl-cholin (PC) was BA (98.2%), followed by MYP (97.3%) and CH (95.5%) (Figure 1). Interestingly, four of five inclusivity test strains lacking PLC reaction also showed atypical colony color due to a lack in ß-D-glucosidase on BRI, HI, or CH agar. Bacillus pseudomycoides (panC group I/toxin profile C) growth was inhibited on MYP, HI and CH (Figure 1). An explanation for this rare atypical observation was provided by Slamti et al. [41], who observed 2% PC-PLC-negative and non-hemolytic test strains due to the absence of PlcR-regulated proteins.
Cross-reactivity for PI-PLC, PC-PLC and β-D-glucosidase was previously observed for Staphylococcus aureus and pathogenic Listeria [37]. In our study, Paenibacillus polymyxa caused PLC cross-reactivity on MYP and BA agar and L. monocytogenes grew on BA. ß-D-glucosidase-positive reaction was observed for a broader range of exclusivity test strains (e.g., enterococci, Listeria, staphylococci, bacilli, Microbacterium and other Gram-negative bacteria) on the tested media (Figure 1 and Figure 3). On BRI, the only agar investigated based on solely one differentiation system (ß-D-glucosidase), several Gram-positive (e.g., Bacillus, staphylococci and enterococci) and Gram-negative (e.g., Enterobacter cloacae, Aeromonas hydrophila and Brevundimonas dimenuta) non-target strains grew despite the addition of polymyxin B in combination with trimethoprim. Lower growth of cocci was observed on BRI in contrast to MYP and HI. However, the proprietary antibiotic mixtures of CH and BA were even superior in selectivity compared to other media.
The detection and differentiation of presumptive B. cereus s.l. can be improved by the parallel use of two complementary selective agars, as it is already standard practice in the detection of L. monocytogenes [42] and Salmonella spp. [43]. The combination of agar media operating on different biochemical principles and characterized by different sensitivity and selectivity (e.g., the highly selective BA or CH with the less selective MYP, BRI, or HI) could allow for a more accurate detection of a broad spectrum of group members in food samples. Since other aerobic spore-formers are also relevant as hygiene indicators in food industry, BRI or HI could be supplemented with egg yolk to detect a broader spectrum of bacilli and improve initial differentiation. Parallel incubation of selective agar plates under mesophilic, psychrophilic, or thermophilic conditions would be recommendable depending on the food type (Figure 7). Incubation at 5–7 °C for the investigation of dairy products may support the assessment of a potential proliferation of bacilli even if the cold chain is maintained [44]. Starch-containing foods as well as herbs and spices have been contaminated with the thermotolerant B. cytotoxicus, as shown in previous reports [45,46]. Therefore, thermophilic (≥45 °C) and mesophilic (30 °C) incubation should be considered for these food categories.
Figure 7.
Proposed workflow for Bacillus cereus sensu lato analysis performable in routine food analysis (Italic—optional steps). COS, Columbia agar plus 5% sheep blood. *, parallel incubation at different temperatures to detect psychrotolerant and thermophilic growth.
In our study, all naturally contaminated samples contained levels of presumptive B. cereus s.l. at the limit of detection. In principle, this finding is reassuring, but when assessing the safety of a product throughout the food production chain, including storage to the end of shelf-life, particularly nutrient-rich products contaminated with low levels of B. cereus s.l. lacking competitive flora cannot be considered completely safe. On the one hand, one can assume low level contaminations in the case of fresh produce, which, however, can result in rapid multiplication and accumulation of emetic and enterotoxins when temperature deviations occur. Moreover, low contamination levels of highly processed foods do not preclude the presence of the heat-stable and acid-stable toxin cereulide at the time of consumption posing a health risk to the consumer [32]. Naturally contaminated food samples from different manufacturers and batches presented very heterogeneous B. cereus s.l. populations. In particular, the diversity of milk isolates between manufacturers was distinctive, which could be attributed to processing methods applied (such as microfiltration and high-temperature treatment) and/or the presence of persister cells in the production environment (Figure 5, Supplementary Tables S5 and S6).
Naturally contaminated samples were pre-screened for the presence of presumptive B. cereus s.l. prior to freezing. Recovery after freezing was tested using the selective media test panel and resulted in the highest recovery on BA (57.8%), CH (56.3%) and MYP (54.7%) (Figure 6). Identical panC group and toxin gene combinations before and after freezing were detected in 20.3% of samples. Sampling before and after freezing revealed shifts in panC groups and toxin gene profiles, but within samples from the same producer the distributions were consistent. In 15.6% of samples, divergent panC and toxin combinations were detected after freezing. This phenomenon can be explained by the non-uniform distribution of B. cereus s.l. contamination at the detection limit (Poisson distribution) and by the influence of matrix components during initial testing [47]. Group species and their toxins may be bound to lipid globules (e.g., in the case of dairy products) and only become detectable following rougher digestion after more stringent sample treatment process procedures, e.g., using such as beads beating [48,49]. In our investigation, freezing samples resulted in the detection of an extended spectrum of panC and toxin profile combinations.
The predominant panC/toxin profile combination among target strains and naturally contaminated sample isolates was IV/A (21.8% and 33.0%, respectively), followed by VI/C (17.3% and 10.4%), III/F and II/F (21.7% and 10.4% in naturally contaminated samples) and III/D (10.9% target strains) (Figure 5 and Supplementary Table S2).
Phylogenetic groups II, III and IV comprise moderately to highly cytotoxic strains, most likely posing a potential health risk. In addition, panC group III strains may carry the ces gene encoding for emetic toxin cereulide [25]. B. cereus s.l. strains assigned to panC group VI were often isolated from raw milk (target strain set) and were highly abundant among heat-treated milk samples (Supplementary Tables S2 and S6) [50].
Recently, the connection of biopesticidal B. thuringiensis strains to foodborne outbreaks in France was investigated. In 39% of outbreaks, B. thuringiensis panC group IV was suspected to be the causative organism [51]. In our study, panC group IV was highly abundant among isolates from salads, vegetables, herbs and spices that may also include biopesticidal B. thuringiensis strains. Furthermore, cytK-2 was highly abundant among panC group IV strains [18,52]. This is concordant with our results as we identified cytK-2 highly abundant in panC/toxin gene profile combination IV/A (21.8% and 33.0% among target strains and sample isolates). Since other studies have found the use of B. thuringiensis biopesticides to be safe or of low risk to public health [53,54], future research should address the contribution of extensively used biopesticide strains to the contamination of raw materials, such as vegetables and fresh produce processed into ready-to-eat foods.
5. Conclusions
This study dealt with culture-based B. cereus s.l. diagnosis, which is especially practiced in routine analysis. We tested a selective media panel using test strains and naturally contaminated samples at the detection limit, which is relevant for practice. The results show that it is necessary to include more than one selective medium in the analysis, comparable to Listeria monocytogens and Salmonella diagnostics in food and animal feed. In order to be able to make a statement about contamination with presumptive B. cereus s.l. at all, it is recommended to perform, e.g., PCR, FTIR or MALDI-based confirmation and subtyping (e.g., panC and toxin gene profiling) and to assess growth behavior (e.g., psychrotolerance) (Figure 7).
Supplementary Materials
The following supporting information can be downloaded at: https://www.mdpi.com/article/10.3390/foods11030288/s1, Table S1: Media specifications according to the respective manufacturer’s descriptions; Table S2: Inclusivity test strains (n = 110); Table S3: Exclusivity test strains (n = 110); Table S4A: Background information on naturally contaminated food samples; Table S4B: Background information on naturally contaminated milk samples; Table S5: Accordance in the detection of Bacillus cereus group in naturally contaminated samples (n = 64) before and after freezing on selective agar media; Table S6: panC group and toxin gene profile combinations of Bacillus cereus group detected before and after freezing (n = 64 samples).
Author Contributions
Conceptualization, E.F. and B.S.; methodology, E.F., C.R. and B.S.; validation, E.F. and B.S.; formal analysis, E.F., B.S. and K.B.; investigation, E.F., C.R. and B.S.; resources, M.W. and B.S.; data curation, E.F., C.R. and B.S.; writing—original draft preparation, B.S. and E.F.; writing—review and editing, B.S., E.F., K.B., M.E.-S. and M.W.; visualization, B.S., K.B. and E.F.; supervision, M.W., M.E.-S. and B.S.; project administration, M.W. and B.S.; funding acquisition, M.W. and B.S. All authors have read and agreed to the published version of the manuscript.
Funding
This research was funded by the Austrian Research Promotion Agency (FFG; Vienna, Austria) collaborative K-project “ADDA-Advancement of Dairying in Austria” under the COMET program (grant number 843543) and the Austrian Economic Chamber (WKO; Vienna, Austria) project “Microbial safety of ethnics foods”.
Acknowledgments
The authors wish to express gratitude to Monika Ehling-Schulz (Institute of Microbiology, University of Veterinary Medicine, Vienna) for kindly providing outbreak strains, oligonucleotide primers and PCR protocols for toxin gene screening and intellectual input. Furthermore, we thank Sonja Muri-Klinger BSc. for excellent technical assistance in the laboratory. Open Access Funding by the University of Veterinary Medicine Vienna.
Conflicts of Interest
The authors declare no conflict of interest.
References
- Kumari, S.; Sarkar, P.K. Bacillus cereus hazard and control in industrial dairy processing environment. Food Control 2016, 69, 20–29. [Google Scholar] [CrossRef]
- Logan, N.A.; De Vos, P. Bacillus. In Bergey’s Manual of Systematics of Archaea and Bacteria; Whitman, W.B., Rainey, F., Kämpfer, P., Trujillo, M., Chun, J., de Vos, P., Hedlund, B., Dedysh, S., Eds.; John Wiley & Sons: Hoboken, NJ, USA, 2015. [Google Scholar]
- Messelhäußer, U.; Ehling-Schulz, M. Bacillus cereus—A Multifaceted Opportunistic Pathogen. Curr. Clin. Microbiol. Rep. 2018, 5, 120–125. [Google Scholar] [CrossRef] [Green Version]
- Ehling-Schulz, M.; Fricker, M.; Scherer, S. Bacillus cereus, the causative agent of an emetic type of food-borne illness. Mol. Nutr. Food Res. 2004, 48, 479–487. [Google Scholar] [CrossRef]
- Ehling-Schulz, M.; Lereclus, D.; Koehler, T.M. The Bacillus cereus Group: Bacillus Species with Pathogenic Potential. Microbiol. Spect. 2019, 7. [Google Scholar] [CrossRef]
- Dietrich, R.; Jessberger, N.; Ehling-Schulz, M.; Märtlbauer, E.; Granum, P.E. The Food Poisoning Toxins of Bacillus cereus. Toxins 2021, 13, 98. [Google Scholar] [CrossRef]
- Lechner, S.; Mayr, R.; Francis, K.P.; Pruess, B.M.; Kaplan, T.; Wießner-Gunkel, E.; Steward, G.S.; Scherer, S. Bacillus weihenstephanensis sp. nov. is a new psychrotolerant species of the Bacillus cereus group. Int. J. Syst. Evol. Microbiol. 1998, 48, 1373–1382. [Google Scholar] [CrossRef] [Green Version]
- Nakamura, L.K. Bacillus pseudomycoides sp. nov. Int. J. Syst. Evol. Microbiol. 1998, 48, 1031–1035. [Google Scholar] [CrossRef] [PubMed] [Green Version]
- Guinebretière, M.H.; Auger, S.; Galleron, N.; Contzen, M.; De Sarrau, B.; De Buyser, M.L.; Lamberet, G.; Fagerlund, A.; Granum, P.E.; Lereclus, D.; et al. Bacillus cytotoxicus sp. nov. is a novel thermotolerant species of the Bacillus cereus Group occasionally associated with food poisoning. Int. J. Syst. Evol. Microbiol. 2013, 63, 31–40. [Google Scholar] [CrossRef] [PubMed]
- Jiménez, G.; Urdiain, M.; Cifuentes, A.; López-López, A.; Blanch, A.R.; Tamames, J.; Kämpfer, P.; Kolstø, A.B.; Ramón, D.; Martínez, J.F.; et al. Description of Bacillus toyonensis sp. nov., a novel species of the Bacillus cereus group, and pairwise genome comparisons of the species of the group by means of ANI calculations. Syst. Appl. Microbiol. 2013, 36, 383–391. [Google Scholar] [CrossRef] [PubMed] [Green Version]
- Fricker, M.; Reissbrodt, R.; Ehling-Schulz, M. Evaluation of standard and new chromogenic selective plating media for isolation and identification of Bacillus cereus. Int. J. Food Microbiol. 2008, 121, 27–34. [Google Scholar] [CrossRef]
- Tallent, S.M.; Kotewicz, K.M.; Strain, E.A.; Bennett, R.W. Efficient Isolation and Identification of Bacillus cereus Group. J. AOAC Int. 2012, 95, 446–451. [Google Scholar] [CrossRef]
- Guinebretière, M.H.; Thompson, F.L.; Sorokin, A.; Normand, P.; Dawyndt, P.; Ehling-Schulz, M.; Svensson, B.; Sanchis, V.; Nguyen-The, C.; Heyndrickx, M.; et al. Ecological diversification in the Bacillus cereus Group. Environ. Microbiol. 2008, 10, 851–865. [Google Scholar] [CrossRef]
- Ehling-Schulz, M.; Messelhäußer, U. Bacillus “next generation” diagnostics: Moving from detection toward subtyping and risk-related strain profiling. Front. Microbiol. 2013, 4, 32. [Google Scholar] [CrossRef] [Green Version]
- Nair, K.; Al-Thani, R.; Al-Thani, D.; Al-Yafei, F.; Ahmed, T.; Jaoua, S. Diversity of Bacillus thuringiensis Strains From Qatar as Shown by Crystal Morphology, δ-Endotoxins and cry Gene Content. Front. Microbiol. 2018, 9, 708. [Google Scholar] [CrossRef] [PubMed]
- Doellinger, J.; Schneider, A.; Stark, T.D.; Ehling-Schulz, M.; Lasch, P. Evaluation of MALDI-ToF mass spectrometry for rapid detection of cereulide from Bacillus cereus cultures. Front. Microbiol. 2020, 11, 2483. [Google Scholar] [CrossRef]
- Ehling-Schulz, M.; Svensson, B.; Guinebretière, M.H.; Lindbäck, T.; Andersson, M.; Schulz, A.; Fricker, M.; Christiansson, A.; Granum, P.E.; Märtlbauer, E.; et al. Emetic toxin formation of Bacillus cereus is restricted to a single evolutionary lineage of closely related strains. Microbiology 2005, 151, 183–197. [Google Scholar] [CrossRef] [PubMed] [Green Version]
- Johler, S.; Kalbhenn, E.M.; Heini, N.; Brodmann, P.; Gautsch, S.; Bağcioğlu, M.; Contzen, M.; Stephan, R.; Ehling-Schulz, M. Enterotoxin Production of Bacillus thuringiensis Isolates From Biopesticides, Foods, and Outbreaks. Front. Microbiol. 2018, 9, 1915. [Google Scholar] [CrossRef] [Green Version]
- Bağcıoğlu, M.; Fricker, M.; Johler, S.; Ehling-Schulz, M. Detection and Identification of Bacillus cereus, Bacillus cytotoxicus, Bacillus thuringiensis, Bacillus mycoides and Bacillus weihenstephanensis via Machine Learning Based FTIR Spectroscopy. Front. Microbiol. 2019, 10, 902. [Google Scholar] [CrossRef]
- Manzulli, V.; Rondinone, V.; Buchicchio, A.; Serrecchia, L.; Cipolletta, D.; Fasanella, A.; Parisi, A.; Difato, L.; Iatarola, M.; Aceti, A.; et al. Discrimination of Bacillus cereus Group Members by MALDI-TOF Mass Spectrometry. Microorganisms 2021, 9, 1202. [Google Scholar] [CrossRef]
- ISO 7932; Microbiology of Food and Animal Feeding Stuffs-Horizontal Method for the Enumeration of Presumptive Bacillus cereus-Colony-Count Technique at 30 °C. International Organization for Standardization: Geneva, Switzerland, 2004.
- Walsh, P.S.; Metzger, D.A.; Higuchi, R. Chelex 100 as a medium for simple extraction of DNA for PCR-based typing from forensic material. Biotechniques 2013, 10, 506–513. [Google Scholar] [CrossRef] [Green Version]
- Dzieciol, M.; Fricker, M.; Wagner, M.; Hein, I.; Ehling-Schulz, M. A novel diagnostic real-time PCR assay for quantification and differentiation of emetic and non-emetic Bacillus cereus. Food Control 2013, 32, 176–185. [Google Scholar] [CrossRef]
- Ehling-Schulz, M.; Guinebretière, M.H.; Monthán, A.; Berge, O.; Fricker, M.; Svensson, B. Toxin gene profiling of enterotoxic and emetic Bacillus cereus. FEMS Microbiol. Lett. 2006, 260, 232–240. [Google Scholar] [CrossRef] [PubMed] [Green Version]
- Guinebretière, M.H.; Velge, P.; Couvert, O.; Carlin, F.; Debuyser, M.L. Ability of Bacillus cereus Group Strains To Cause Food Poisoning Varies According to Phylogenetic Affiliation (Groups I to VII) Rather than Species Affiliation. J. Clin. Microbiol. 2010, 48, 3388–3391. [Google Scholar] [CrossRef] [Green Version]
- R Development Core Team. R: A Language and Environment for Statistical Computing; R Foundation for Statistical Computing: Vienna, Austria, 2021; ISBN 3-900051-07-0. Available online: http://www.R-project.org (accessed on 17 December 2021).
- Glasset, B.; Herbin, S.; Granier, S.A.; Cavalié, L.; Lafeuille, E.; Guérin, C.; Ruimy, R.; Casagrande-Magne, F.; Levast, M.; Chautemps, N.; et al. Bacillus cereus, a serious cause of nosocomial infections: Epidemiologic and genetic survey. PLoS ONE 2018, 13, e0194346. [Google Scholar] [CrossRef]
- Thorsen, L.; Budde, B.B.; Henrichsen, L.; Martinussen, T.; Jakobsen, M. Cereulide formation by Bacillus weihenstephanensis and mesophilic emetic Bacillus cereus at temperature abuse depends on pre-incubation conditions. Int. J. Food Microbiol. 2009, 134, 133–139. [Google Scholar] [CrossRef]
- Saleh-Lakha, S.; Leon-Velarde, C.G.; Chen, S.; Lee, S.; Shannon, K.; Fabri, M.; Downing, G.; Keown, B. A Study To Assess the Numbers and Prevalence of Bacillus cereus and Its Toxins in Pasteurized Fluid Milk. J. Food Prot. 2017, 80, 1085–1089. [Google Scholar] [CrossRef]
- Park, K.M.; Kim, H.J.; Jeong, M.; Koo, M. Enterotoxin Genes, Antibiotic Susceptibility, and Biofilm Formation of Low-Temperature-Tolerant Bacillus cereus Isolated from Green Leaf Lettuce in the Cold Chain. Foods 2020, 9, 249. [Google Scholar] [CrossRef] [PubMed] [Green Version]
- Rouzeau-Szynalski, K.; Stollewerk, K.; Messelhäußer, U.; Ehling-Schulz, M. Why be serious about emetic Bacillus cereus: Cereulide production and industrial challenges. Food Microbiol. 2020, 85, 103279. [Google Scholar] [CrossRef]
- Messelhäußer, U.; Frenzel, E.; Blöchinger, C.; Zucker, R.; Kämpf, P.; Ehling-Schulz, M. Emetic Bacillus cereus Are More Volatile Than Thought: Recent Foodborne Outbreaks and Prevalence Studies in Bavaria (2007–2013). BioMed Res. Int. 2014, 2014, 465603. [Google Scholar] [CrossRef] [PubMed] [Green Version]
- Warda, A.K.; Siezen, R.J.; Boekhorst, J.; Wells-Bennik, M.H.; de Jong, A.; Kuipers, O.P.; Nierop Groot, M.N.; Abee, T. Linking Bacillus cereus Genotypes and Carbohydrate Utilization Capacity. PLoS ONE 2016, 11, e0156796. [Google Scholar] [CrossRef]
- Hendriksen, N.B.; Hansen, B.M. Diagnostic properties of three conventional selective plating media for selection of Bacillus cereus, B. thuringiensis and B. weihenstephanensis. Folia Microbiol. 2011, 56, 535–539. [Google Scholar] [CrossRef]
- Chon, J.W.; Song, K.Y.; Kim, H.; Seo, K.H. Comparison of 3 Selective Media for Enumeration of Bacillus cereus in Several Food Matrixes. J. Food Sci. 2014, 79, M2480–M2484. [Google Scholar] [CrossRef]
- Kabir, M.S.; Hsieh, Y.H.; Simpson, S.; Kerdahi, K.; Sulaiman, I.M. Evaluation of Two Standard and Two Chromogenic Selective Media for Optimal Growth and Enumeration of Isolates of 16 Unique Bacillus Species. J. Food Prot. 2017, 80, 952–962. [Google Scholar] [CrossRef]
- Chon, J.W.; Seo, K.H. Development of a new chromogenic medium for the enumeration of Bacillus cereus in various ready-to-eat foods. Food Control 2021, 128, 108188. [Google Scholar] [CrossRef]
- López, A.C.; Alippi, A.M. Phenotypic and genotypic diversity of Bacillus cereus isolates recovered from honey. Int. J. Food Microbiol. 2007, 117, 175–184. [Google Scholar] [CrossRef]
- Chaves, J.Q.; Pires, E.S.; Vivoni, A.M. Genetic diversity, antimicrobial resistance and toxigenic profiles of Bacillus cereus isolated from food in Brazil over three decades. Int. J. Food Microbiol. 2011, 147, 12–16. [Google Scholar] [CrossRef]
- Miller, R.A.; Jian, J.; Beno, S.M.; Wiedmann, M.; Kovac, J. Intraclade Variability in Toxin Production and Cytotoxicity of Bacillus cereus Group Type Strains and Dairy-Associated Isolates. Appl. Environ. Microbiol. 2018, 84, e02479-17. [Google Scholar] [CrossRef] [PubMed] [Green Version]
- Slamti, L.; Perchat, S.; Gominet, M.; Vilas-Bôas, G.; Fouet, A.; Mock, M.; Sanchis, V.; Chaufaux, J.; Gohar, M.; Lereclus, D. Distinct Mutations in PlcR Explain Why Some Strains of the Bacillus cereus Group Are Nonhemolytic. J. Bacteriol. 2004, 186, 3531–3538. [Google Scholar] [CrossRef] [PubMed] [Green Version]
- ISO 11290; Microbiology of the Food Chain-Horizontal Method for the Detection and Enumeration of Listeria monocytogenes and of Listeria spp.—Part 1: Detection Method. International Organization for Standardization: Geneva, Switzerland, 2017.
- ISO 6579; Microbiology of the Food Chain-Horizontal Method for the Detection, Enumeration and Serotyping of Salmonella—Part 1: Detection of Salmonella spp. International Organization for Standardization: Geneva, Switzerland, 2017.
- Webb, M.D.; Barker, G.C.; Goodburn, K.E.; Peck, M.W. Risk presented to minimally processed chilled foods by psychrotrophic Bacillus cereus. Trends Food Sci. Technol. 2019, 93, 94–105. [Google Scholar] [CrossRef]
- Cairo, J.; Gherman, I.; Day, A.; Cook, P.E. Bacillus cytotoxicus-A potentially virulent food-associated microbe. J. Appl. Microbiol. 2021, 132, 31–40. [Google Scholar] [CrossRef]
- Heini, N.; Stephan, R.; Ehling-Schulz, M.; Johler, S. Characterization of Bacillus cereus group isolates from powdered food products. Int. J. Food Microbiol. 2018, 283, 59–64. [Google Scholar] [CrossRef] [Green Version]
- Porcellato, D.; Narvhus, J.; Skeie, S.B. Detection and quantification of Bacillus cereus group in milk by droplet digital PCR. J. Microbiol. Methods 2016, 127, 1–6. [Google Scholar] [CrossRef]
- Ramarao, N.; Tran, S.L.; Marin, M.; Vidic, J. Advanced methods for detection of Bacillus cereus and its pathogenic factors. Sensors 2020, 20, 2667. [Google Scholar] [CrossRef] [PubMed]
- Walser, V.; Kranzler, M.; Dawid, C.; Ehling-Schulz, M.; Stark, T.D.; Hofmann, T.F. Distribution of the Emetic Toxin Cereulide in Cow Milk. Toxins 2021, 13, 528. [Google Scholar] [CrossRef] [PubMed]
- Porcellato, D.; Aspholm, M.; Skeie, S.B.; Mellegård, H. Application of a novel amplicon-based sequencing approach reveals the diversity of the Bacillus cereus group in stored raw and pasteurized milk. Food Microbiol. 2019, 81, 32–39. [Google Scholar] [CrossRef]
- Bonis, M.; Felten, A.; Pairaud, S.; Dijoux, A.; Maladen, V.; Mallet, L.; Radomski, N.; Duboisset, A.; Arar, C.; Sarda, X.; et al. Comparative phenotypic, genotypic and genomic analyses of Bacillus thuringiensis associated with foodborne outbreaks in France. PLoS ONE 2021, 16, e0246885. [Google Scholar] [CrossRef] [PubMed]
- Schwenk, V.; Riegg, J.; Lacroix, M.; Märtlbauer, E.; Jessberger, N. Enteropathogenic potential of Bacillus thuringiensis isolates from soil, animals, food and biopesticides. Foods 2020, 9, 1484. [Google Scholar] [CrossRef]
- Raymond, B.; Federici, B.A. In defence of Bacillus thuringiensis, the safest and most successful microbial insecticide available to humanity-a response to EFSA. FEMS Microbiol. Ecol. 2017, 93, fix084. [Google Scholar] [CrossRef] [PubMed] [Green Version]
- De Bock, T.; Zhao, X.; Jacxsens, L.; Devlieghere, F.; Rajkovic, A.; Spanoghe, P.; Höfte, M.; Uyttendaele, M. Evaluation of B. thuringiensis-based biopesticides in the primary production of fresh produce as a food safety hazard and risk. Food Control 2021, 130, 108390. [Google Scholar] [CrossRef]
Publisher’s Note: MDPI stays neutral with regard to jurisdictional claims in published maps and institutional affiliations. |
© 2022 by the authors. Licensee MDPI, Basel, Switzerland. This article is an open access article distributed under the terms and conditions of the Creative Commons Attribution (CC BY) license (https://creativecommons.org/licenses/by/4.0/).